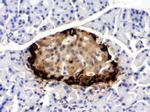
GLP-1 Antibody in Immunohistochemistry (Paraffin) (IHC (P))

Search
Invitrogen
GLP-1 Polyclonal Antibody
{{$productOrderCtrl.translations['antibody.pdp.commerceCard.promotion.promotions']}}
{{$productOrderCtrl.translations['antibody.pdp.commerceCard.promotion.viewpromo']}}
{{$productOrderCtrl.translations['antibody.pdp.commerceCard.promotion.promocode']}}: {{promo.promoCode}} {{promo.promoTitle}} {{promo.promoDescription}}. {{$productOrderCtrl.translations['antibody.pdp.commerceCard.promotion.learnmore']}}
图: 1 / 5
GLP-1 Antibody (PA5-79303) in IHC (P)

产品信息
PA5-79303
种属反应
已发表种属
宿主/亚型
分类
类型
抗原
偶联物
形式
浓度
纯化类型
保存液
内含物
保存条件
运输条件
RRID
产品详细信息
Reconstitute with 0.2 mL of distilled water to yield a concentration of 500 µg/mL.
Positive Control - IHC: mouse pancreas tissue, rat pancreas tissue, human pancreatic cancer tissue.
靶标信息
GCG is also known as GLP1, or Glucagon. Glucagon is a 29-amino acid pancreatic hormone that counteracts the glucose-lowering action of insulin by stimulating glycogenolysis and gluconeogenesis.It is mapped to 2q36-2q37. GLP1, also known as 7-37 for the codons of the preproglucagon molecule which encode it, renders pancreatic beta-cells 'glucose-competent' and may be useful in the treatment of noninsulin-dependent diabetes mellitus. Also, GLP1 is a potent insulin secretagogue.It plays a major role in the enteroinsular axis, accounting, for example, for the finding that plasma insulin levels accompanying oral intake of glucose are greater than those observed when glucose is given intravenously.
仅用于科研。不用于诊断过程。未经明确授权不得转售。
生物信息学
蛋白别名: glicentin-related polypeptide; GLP1/2; glucagon; Glucagon like peptide 1; glucagon-like peptide 1; glucagon-like peptide 2; glucagon-like peptide-1; MGC138331; OXY; preproglucagon; Pro-glucagon
基因别名: GCG; GLP-1; GLP1; GLP2; Glu; GRPP; PPG
UniProt ID: (Human) P01275, (Mouse) P55095
Entrez Gene ID: (Human) 2641, (Mouse) 14526, (Rat) 24952




